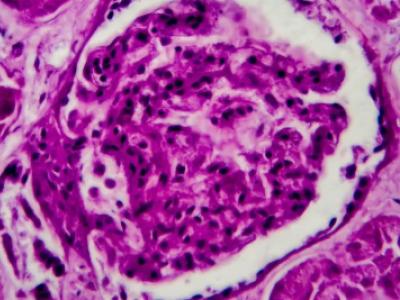

Systemic sclerosis current therapy: - early dcSSc: MMF, CTX, RTX, TCZ - rapidly progressive dcSSc - ?Stem cell transpl?
Tweet Content
Systemic sclerosis current therapy:
- early dcSSc: MMF, CTX, RTX, TCZ
- rapidly progressive dcSSc - ?Stem cell transpl?
- SSc-ILD: MMF>CTX, possibly nintedanib, perfinidone
- Raynauds w/ digital ulcers: CA channel block, PDE5 inhib, iloprost, Bosentan https://t.co/z4OzFklrcl https://t.co/bM01inV2QY